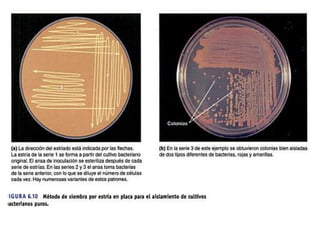

Incrustar presentación
Descargado 20 veces





























Este documento analiza los requerimientos básicos para la nutrición microbiana, incluyendo el efecto Pasteur, la actividad metabólica microbiana y los productos finales del catabolismo microbiano. Examina procesos como la fermentación microbiana, los metabolitos secundarios, la tasa de crecimiento y esquemas generales del metabolismo como el ciclo de Krebs y el ciclo del glioxitato, con el objetivo de analizar y describir su importancia.